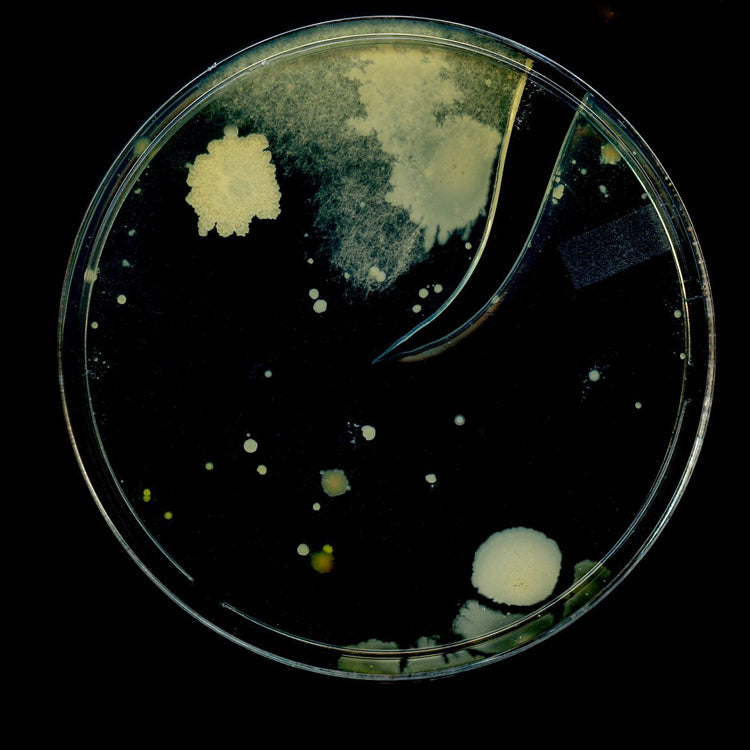
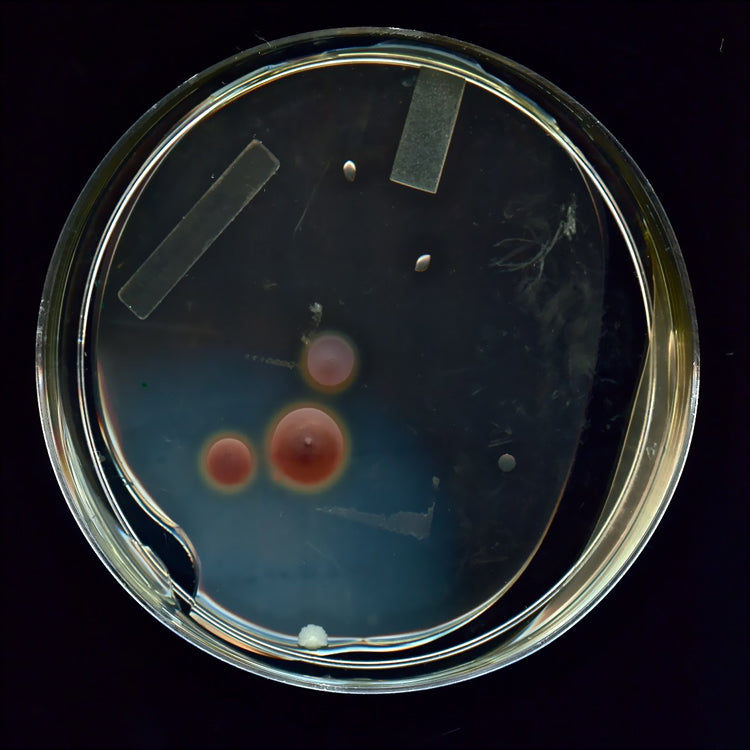
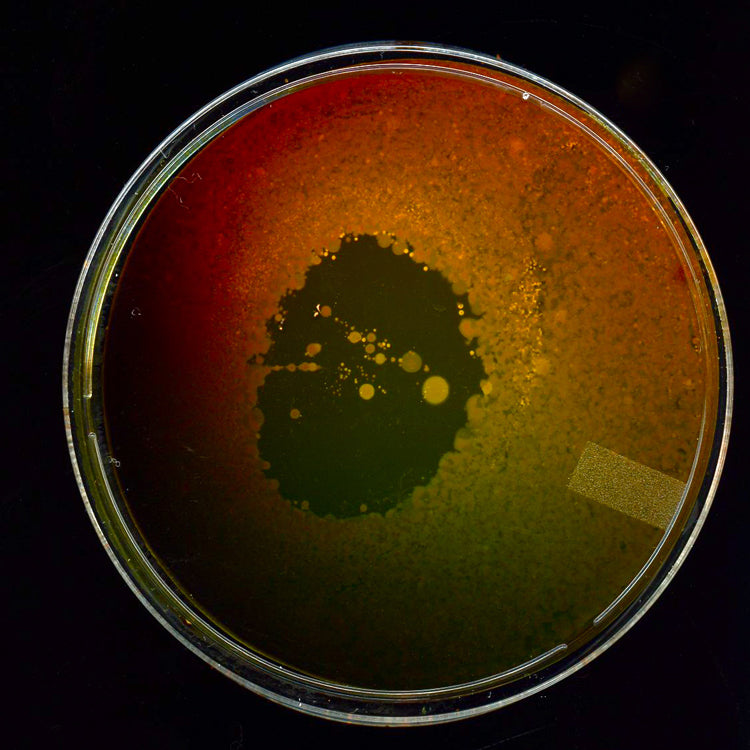
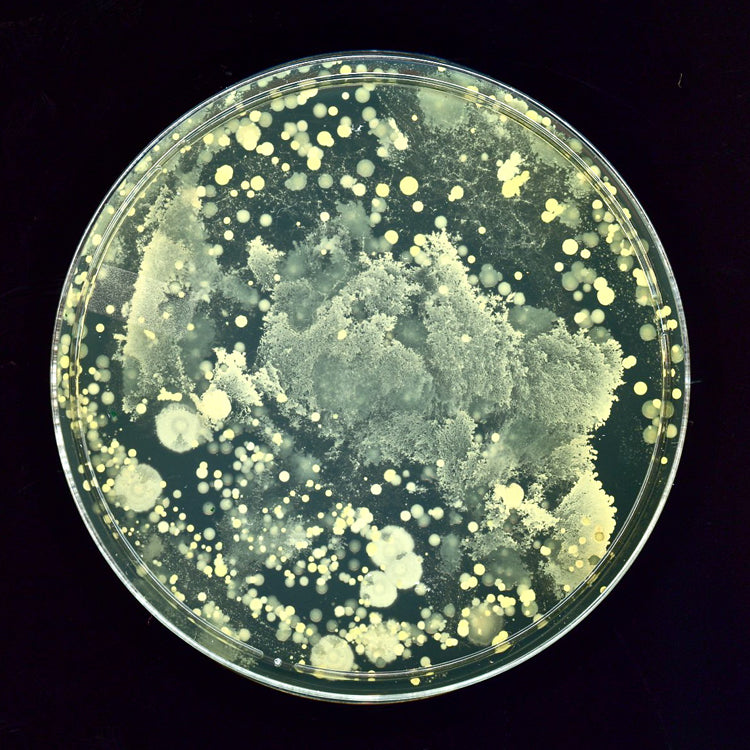

QUALITÄTSKONTROLLE TESTEN BATTERIE
Mikrobiologische Daten
Verwendung von Mikroorganismen. Wie verwendet man sie? Verdünnen Sie sie mit sauberem Wasser, dem natürlichsten Wasser, das Sie bekommen können.
Um 1:50 Uhr, um die Pflanzen zu bewässern (düngen und Schädlinge bekämpfen)
Im Verhältnis 1:100 zum Waschen von Böden (keine Anwesenheit von Coliformen zulassen)
Um 1:20 Uhr Geschirr spülen (mit viel weniger Spülmittel als vorher)
Im Verhältnis 1:200 sprühen und so die Luft und das Klima in Ihrem Haus oder Garten verbessern
Um 1:10 Uhr können Sie sie einnehmen, um Ihre innere Mikroflora zu verbessern, es sind Probiotika
Die oben genannten Hinweise sind Anhaltspunkte, eine Erhöhung der Konzentration kann nicht schaden.
Probiotische Wirksamkeit
Biofermentation: Dieser Stoffwechselprozess, mit dem Bakterien Energie für Zellwachstum und -vermehrung gewinnen, dient der Kultivierung unserer probiotischen Stämme. Bakterien sind empfindlich. Um ihre Lebensfähigkeit zu gewährleisten, müssen sie sorgfältig kultiviert werden. Wir optimieren die Biofermentationsbedingungen hinsichtlich pH-Wert, Stammreinheit, Temperatur und 28 weiteren Faktoren.
Gesunder Boden und Körper
Das Leben auf unserem Planeten begann mit der Arbeit nützlicher Mikroorganismen – jene, die Sonnenenergie einfangen und in lebendige Materie umwandeln, Schadgase aufnehmen und in Sauerstoff verwandeln, Stickstoff aus der Luft sowie Mineralien aus Gestein lösen, um sie für Pflanzen und alle anderen Lebewesen verfügbar zu machen.
Diese Mikroorganismen sind kleine Energiewerke, Produzenten von Nahrung und wichtigen Bodenelementen. Im menschlichen Körper unterstützen sie die Verdauung und die Herstellung lebenswichtiger Substanzen, die vom Organismus aufgenommen werden können.
Ohne nützliche Mikroorganismen wäre unser Leben nicht möglich!
Testen
Überlebensfähigkeit der Verdauung
Um die Überlebensrate unserer Probiotika zu bewerten, testen wir sie mit einem Simulator des menschlichen mikrobiellen Ökosystems im Darm – dem System, das die menschliche Verdauung und den Darm am besten nachbildet. Es bildet die physiologischen Bedingungen und biologischen Prozesse (Nahrungsaufnahme, Peristaltik, Verdauungsenzyme, Pankreas- und Gallensäure sowie die für jeden Schritt benötigte Zeit) nach, die für den menschlichen Magen-Darm-Trakt typisch sind.

Testen
Thermostabilität
Hitze schädigt oder tötet lebende Probiotika typischerweise. Die Auswahl der probiotischen Stämme und deren Transportsystem (z. B. Kapseln, Pulver, Flüssigkeiten) reagieren jedoch unterschiedlich auf unterschiedliche Hitzeeinwirkung. Wir haben unsere Stämme auf die Verpackung und die schlimmsten Hitzebedingungen getestet, die auf dem Weg zu unseren Kunden auftreten könnten.
Sogar nach 10 Tagen konstanter, 24-stündiger Exposition bei 38 °C (100 °F), was selbst in der Sommerhitze sehr unwahrscheinlich ist, überstiegen unsere probiotischen Bakterienzahlen und ihre Lebensfähigkeit die auf unserem Etikett angegebene Anzahl lebender Zellen (AFU).
Nur bei ständiger Einwirkung von glühenden Temperaturen von 49 °C (120 °F) – ununterbrochen über 48 Stunden – sank die Gesamtbiopotenz unter die auf dem Etikett angegebenen Werte und Anforderungen.


Testen
Schwermetalle und Pestizide
Die meisten Nahrungsergänzungsmittel, Obst, Gemüse und Naturprodukte enthalten Schwermetalle. Diese lassen sich nur schwer vollständig aus der Ernährung eliminieren, da sie von Pflanzen über Luft, Wasser und Boden aufgenommen werden und nachweislich Krebs oder reproduktionstoxische Wirkungen haben. Longevitylife hält sich an diese strengen Vorschriften und testet alle Produkte auf die vier Hauptkategorien von Schwermetallen: Arsen, Cadmium, Blei und Quecksilber.
Unser natürlicher Regenwald, in dem alle unsere Produkte von Hand angebaut werden, wird seit 1990 getestet und ist frei von Schwermetallen und Pestiziden. Wir verwenden ausschließlich natürliche Materialien und alte Maya-Landwirtschaftstechniken